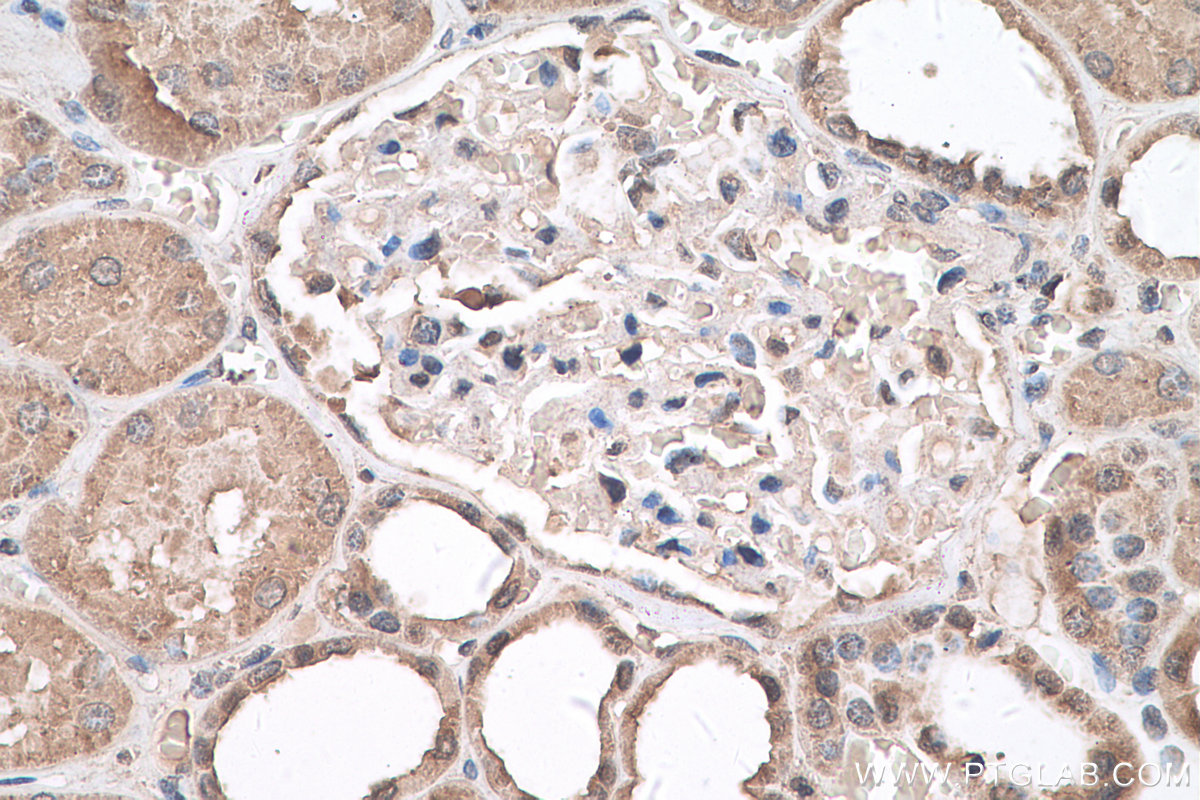

验证数据展示
产品信息
67949-1-PBS targets HDAC11 in WB, IHC, Indirect ELISA applications and shows reactivity with Human samples.
| 经测试应用 | WB, IHC, Indirect ELISA Application Description |
| 经测试反应性 | Human |
| 免疫原 |
CatNo: Ag28335 Product name: Recombinant human HDAC11 protein Source: e coli.-derived, PET28a Tag: 6*His Domain: 1-347 aa of BC009676 Sequence: MLHTTQLYQHVPETRWPIVYSPRYNITFMGLEKLHPFDAGKWGKVINFLKEEKLLSDSMLVEAREASEEDLLVVHTRRYLNELKWSFAVATITEIPPVIFLPNFLVQRKVLRPLRTQTGGTIMAGKLAVERGWAINVGGGFHHCSSDRGGGFCAYADITLAIKFLFERVEGISRATIIDLDAHQGNGHERDFMDDKRVYIMDVYNRHIYPGDRFAKQAIRRKVELEWGTEDDEYLDKVERNIKKSLQEHLPDVVVYNAGTDILEGDRLGGLSISPAGIVKRDELVFRMVRGRRVPILMVTSGGYQKRTARIIADSILNLFGLGLIGPESPSVSAQNSDTPLLPPAVP 种属同源性预测 |
| 宿主/亚型 | Mouse / IgG1 |
| 抗体类别 | Monoclonal |
| 产品类型 | Antibody |
| 全称 | histone deacetylase 11 |
| 别名 | FLJ22237, HD11, HDAC11, histone deacetylase 11 |
| 计算分子量 | 347 aa, 39 kDa |
| 观测分子量 | 39 kDa |
| GenBank蛋白编号 | BC009676 |
| 基因名称 | HDAC11 |
| Gene ID (NCBI) | 79885 |
| RRID | AB_2918701 |
| 偶联类型 | Unconjugated |
| 形式 | Liquid |
| 纯化方式 | Protein G purification |
| UNIPROT ID | Q96DB2 |
| 储存缓冲液 | PBS only, pH 7.3. |
| 储存条件 | Store at -80°C. The product is shipped with ice packs. Upon receipt, store it immediately at -80°C |
背景介绍
Histone deacetylases(HDAC) are a class of enzymes that remove the acetyl groups from the lysine residues leading to the formation of a condensed and transcriptionally silenced chromatin. At least 4 classes of HDAC were identified. HDAC11 belongs to Class IV HDACs. HDAC11 is localized to the nucleus and may be involved in regulating the expression of interleukin 10. Alternative splicing results in multiple transcript variants. HDAC11 has 2 isoforms with the molecular mass of 33 and 39 kDa.